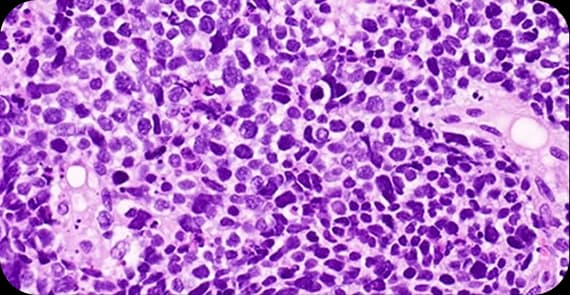
Small Cell Carcinoma

A diagnosis of prostate cancer can be concerning, particularly because the prostate plays an important role in male reproductive health. Prostate cancer develops when abnormal cells grow uncontrollably in the prostate gland, which is located below the bladder and surrounds the urethra.
Alongside conventional approaches such as prostate cancer surgery, radiation therapy, hormone therapy, chemotherapy, targeted therapy, and immunotherapy, many patients explore complementary and alternative medicine (CAM) approaches as supportive care to improve strength, immune balance, and overall wellbeing during treatment.
Diagnosed with prostate cancer? Dr. Tarang offers personalised, integrative treatment planning grounded in clinical oncology experience.
When patients ask what prostate cancer is, the explanation begins at the cellular level. Prostate cancer occurs when cells within the prostate gland develop genetic mutations that lead to uncontrolled growth and division.
In many cases, prostate cancer grows slowly and may remain confined to the gland for years. However, some forms are more aggressive and can spread to nearby tissues, lymph nodes, or bones.
Understanding what happens in prostate cancer helps guide a timely diagnosis and appropriate treatment planning.
There are different types of prostate cancer depending on the cells from which the tumour arises.
The most common type, originating in the glandular cells of the prostate.
A rare and more aggressive subtype.
These rare forms arise from hormone-producing cells.
Include transitional cell carcinoma and sarcomas.
Prostate cancer symptoms may not appear in early stages. In many cases, the disease is detected through routine screening.
Common Signs of Prostate Cancer
Difficulty starting or stopping urination
Weak or interrupted urine flow
Frequent urination, especially at night
Blood in urine or semen
Pelvic discomfort
Bone pain in advanced stages
Early signs of prostate cancer are often mild or absent. Recognising signs of prostate cancer and undergoing appropriate screenings can help with early detection.
The exact prostate cancer causes are not always clear. The condition typically develops due to a combination of genetic, hormonal, and environmental factors.
Reasons for prostate cancer may include:
Genetic mutations
Hormonal influences, particularly testosterone
Family history
Increasing age
Lifestyle factors
While there is no single identifiable cause in most cases, understanding risk factors supports prevention and monitoring.
Several factors increase the likelihood of developing prostate cancer.
Common risk factors include:
Age over 50
Family history of prostate cancer
Certain inherited genetic mutations
Obesity
Sedentary lifestyle
Regular screening may be recommended for individuals at higher risk.
Prostate cancer stages describe how far the cancer has spread.
Cancer confined to the prostate and often detected incidentally.
The cancer is still confined to the prostate but larger in size.
Spread beyond the prostate capsule to nearby tissues.
This refers to metastatic prostate cancer, which has spread to lymph nodes, bones, or other organs.
Prostate cancer stages guide decisions regarding prostate cancer treatment and prognosis.
Prostate cancer diagnosis involves screening tests and confirmatory evaluation.
The diagnostic process may include:
Prostate-specific antigen (PSA) blood test
Digital rectal examination
MRI imaging
Prostate biopsy
Bone scan or CT scan in advanced cases
A precise prostate cancer diagnosis allows for stage-specific and personalised treatment planning.
Prostate cancer treatment depends on stage, tumour aggressiveness, and overall health.
Common prostate cancer treatments include:
Active surveillance: Monitors slow-growing cancer without immediate intervention
Prostate cancer surgery: Removes the prostate gland and surrounding tissue
Radiation therapy: Uses high-energy beams to destroy cancer cells
Hormone therapy: Reduces testosterone levels that fuel cancer growth
Chemotherapy: Uses anti-cancer drugs to destroy rapidly dividing cells
Targeted therapy: Focuses on specific genetic or molecular features of cancer cells
Immunotherapy: Stimulates the immune system to recognise and attack cancer cells
Many patients receive a combination of therapies depending on disease stage. Support during systemic treatments is important to maintain strength and overall wellbeing.
Complex prostate cancer cases need tailored care. Dr. Tarang integrates standard and supportive therapies into personalised plans.
Explore Integrative Cancer Treatment Options
Alongside conventional prostate cancer treatment, integrative supportive care may enhance resilience and quality of life. The Cancer Healer Therapy Program combines complementary and alternative medicine with evidence-based oncology care.
This approach may include:
Immune system support during chemotherapy or hormone therapy
Stress reduction and mind-body practices
Carefully supervised herbal or traditional medicine components
Personalised therapy planning aligned with medical treatment
The goal is to support patients throughout their treatment journey without replacing evidence-based therapies.
Many patients ask whether prostate cancer is curable. The answer depends largely on stage and tumour aggressiveness.
Prostate cancer is one of the most common cancers among men worldwide. In India, incidence is rising due to increased screening and ageing populations.
Early-stage prostate cancer confined to the gland is often highly treatable.
Locally advanced disease may require combined therapy.
Metastatic prostate cancer may be managed long-term with systemic treatments.
Early signs of prostate cancer may include urinary changes such as weak flow or frequent urination.
Stay in touch with us to get latest news and special offers.